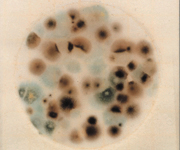

| 图片 | 编号 | 型号 | 规格 | 数量 |
|---|---|---|---|---|
![]() ![]() ![]() ![]() | C6-8641-01 | 6400AC | 菌落总数测试片※ | 50片/包 |
![]() ![]() ![]() ![]() | C6-8641-02 | 6410CC | 大肠菌群数测试片※ | 25片/包 |
![]() ![]() ![]() ![]() | C6-8641-03 | 6404EC | E.coli及大肠菌群/大肠杆菌测试片※ | 25片/包 |
![]() ![]() ![]() ![]() | C6-8641-08 | 6407YM | 霉菌・酵母测试片 | 50片/包 |
![]() ![]() ![]() | C6-8641-12 | 6420EB | 肠杆菌科测试片 | 25片/包 |
![]() | C6-8641-18 | 6490STX | 金黄色葡萄球菌测试片※ | 25片/包 |
![]() | C6-8641-20 | 6492STX | 金黄色葡萄球菌硧认反应片※ | 20片/包 |